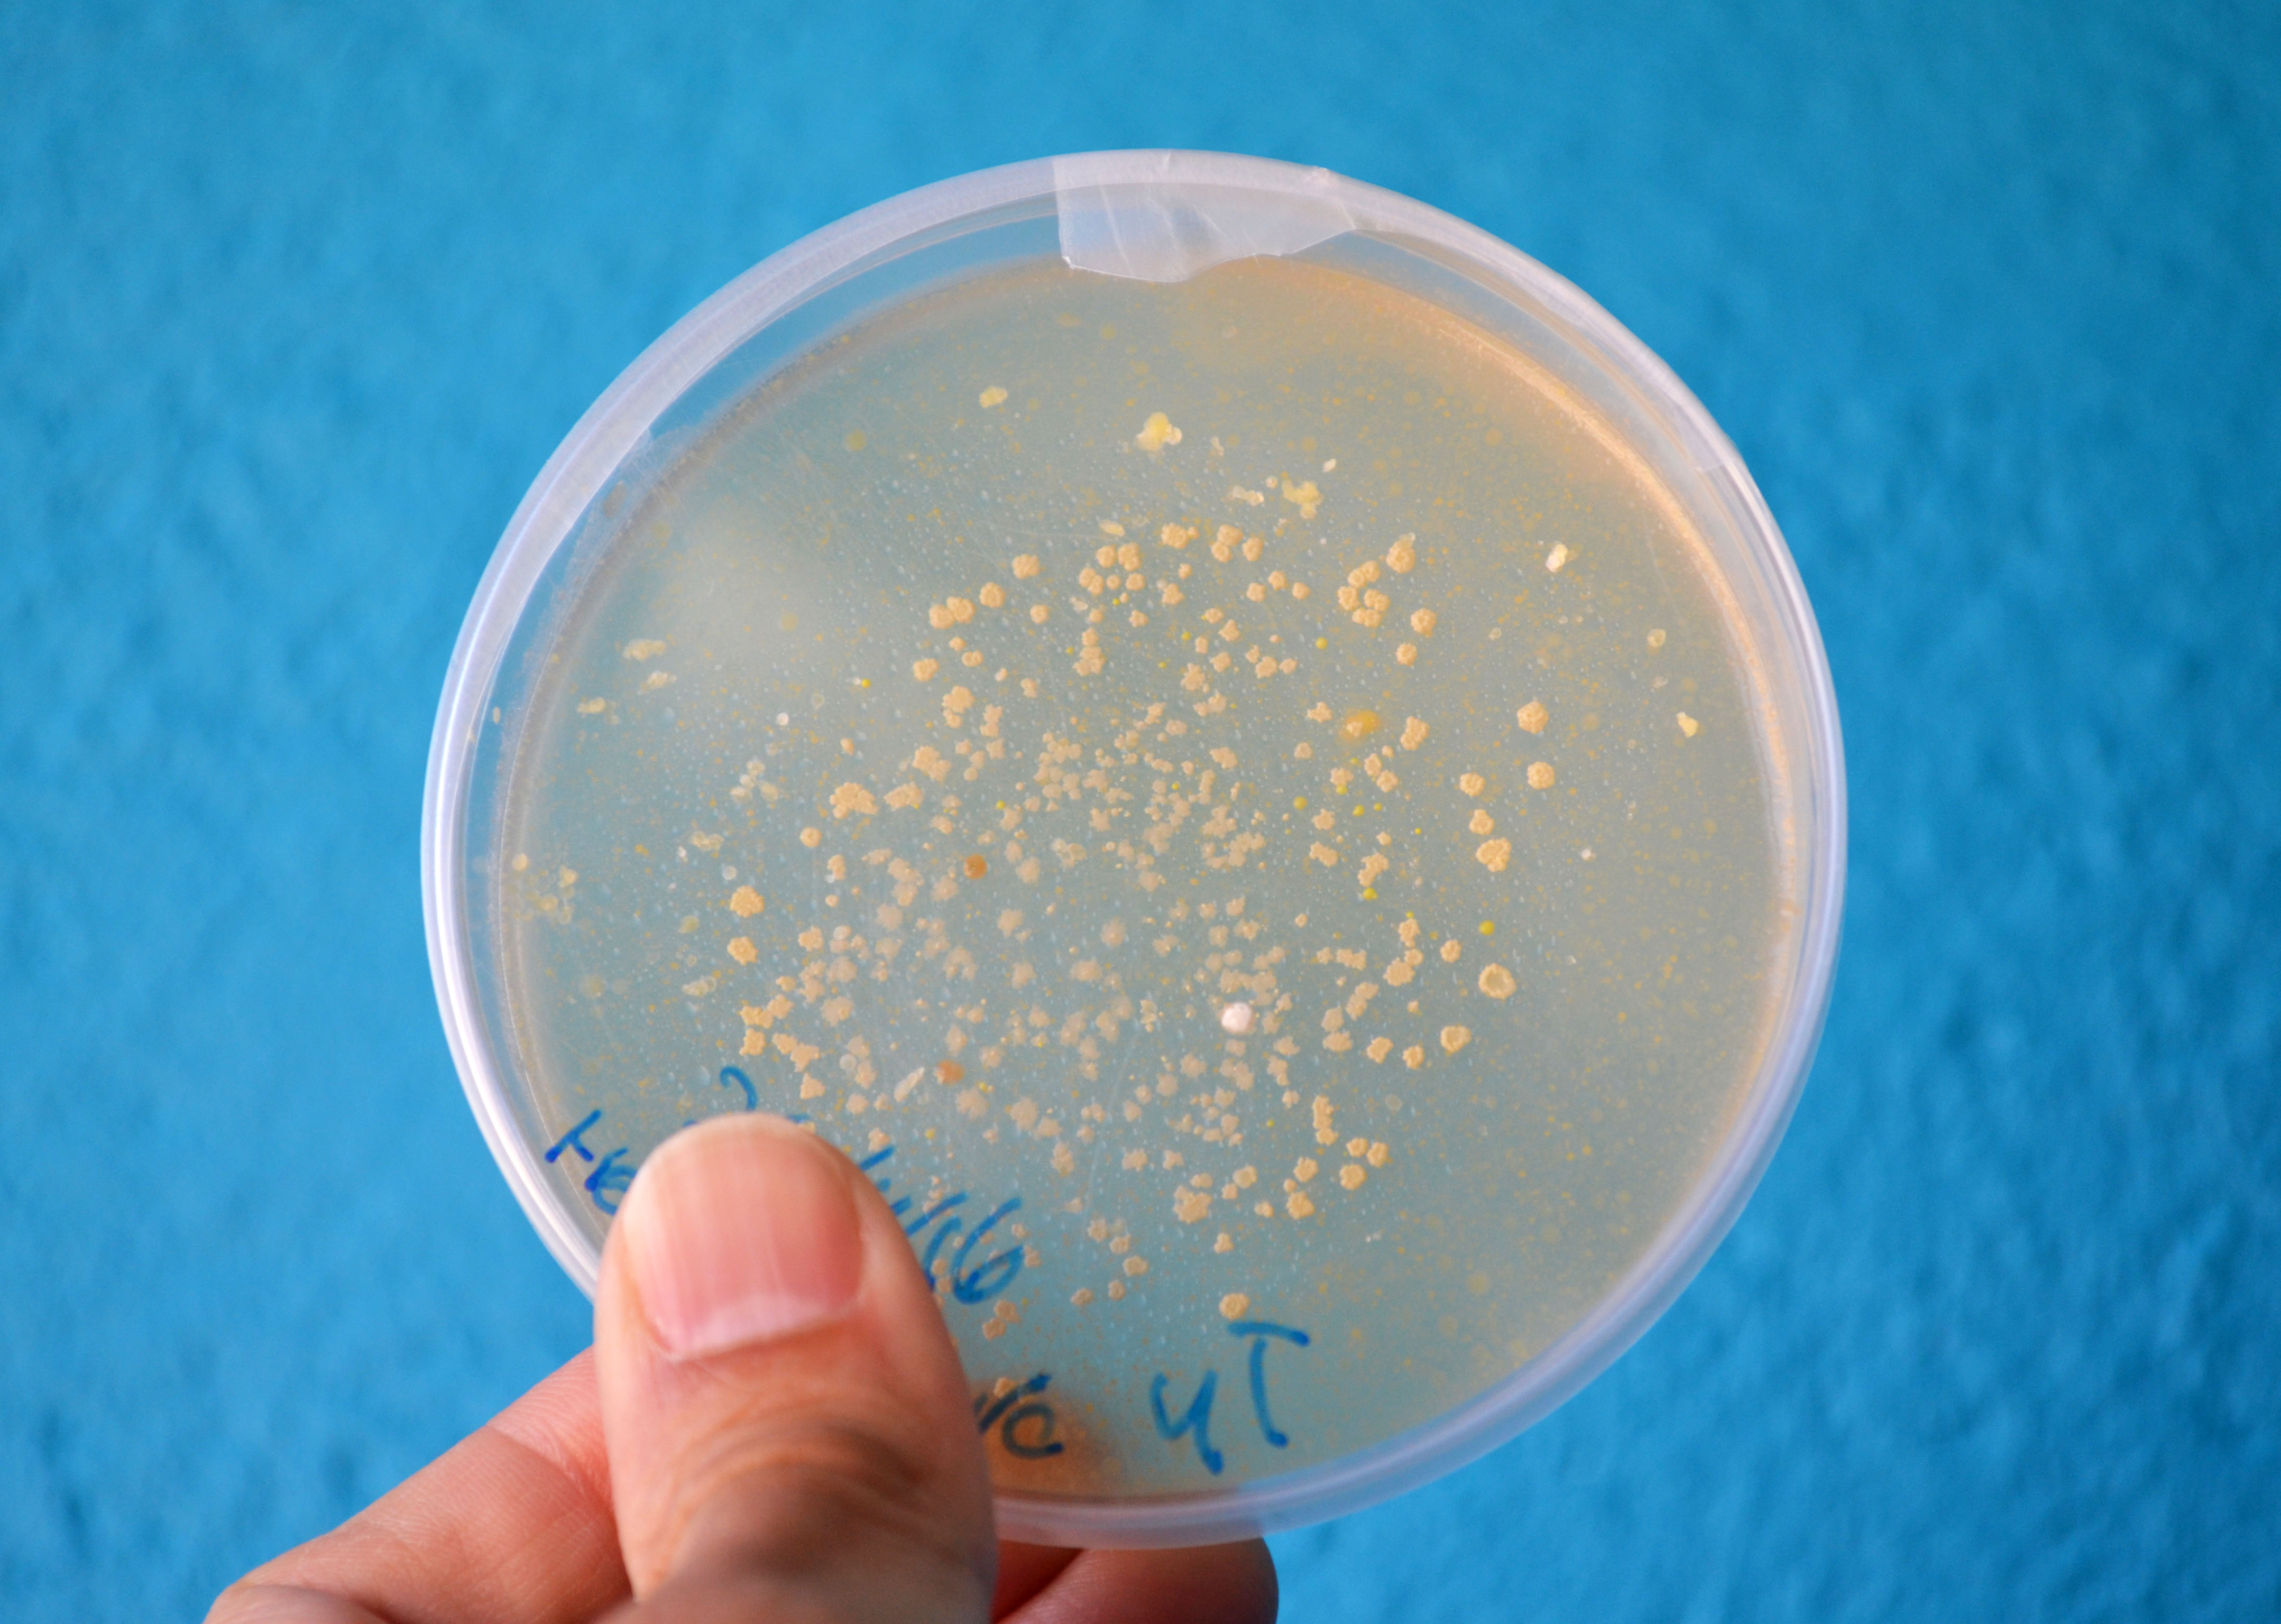

Search for:
Recent Posts
Follow me on Twitter
My TweetsADN
Artròpodes
Badalona
Barcelona
Bee-Bot
Biblioteques
Biologia
Blue-Bot
Bombolles
Botànica
Calidoscopi
Cambra Fosca
Cicle Inicial
Cicle Mitjà
Circuits elèctrics
Colors
Criptoanàlisi
Cromatografia
Crustacis
Cèl·lula
Dactiloscòpia
Densitat
Drawbot
Educació Primària
Electricitat
electrònica
Empremtes dactilars
Espirògraf
Extraescolars
Fluids
Física
Geometria
Hidràulica
Il·lusió Òptica
Imants
Insectes
K'Nex
LED
LEGO
Lents
littleBits
Llum
Magnetisme
Makeblock
mBot
Mecànica
micro:bit
Microscopi
Microscòpia
Miralls
Molècules
Motors
Música
Nadal
Newton
Origami
Periscopi
pH
Picoboard
PlayDoh
Pro-Bot
Programació
Química
Robòtica
Scratch
Squishy Circuits
STEAM
STEM
Tallers
Tecnologia
Tensió Superficial
Throwie
wearables
Zoologia
Òptica
 LAB CLUB
LAB CLUB